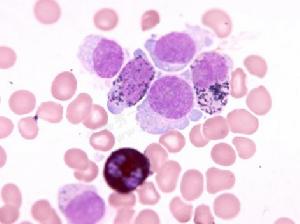
細胞化學染色
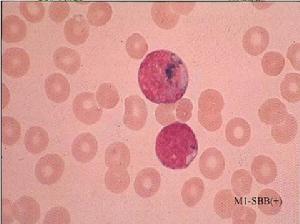
細胞化學染色

染色流程
 細胞化學染色
細胞化學染色固定有物理法與化學法,物理法為乾燥和火焰固定,化學法最常用的是甲醛、乙醇、丙酮和醋酸等。
(二)顯示
1、偶氮偶聯法:利用人工合成的酶底物,在酶作用下,產生分解產物,再與重氮鹽結合引起偶氮偶聯,使其形成不溶性的偶氮色素,以此證明酶的存在。
2、聯苯胺法:粒細胞和單核細胞中的過氧化物酶作用於過氧化氫,釋放新生態氧,使無色的聯苯胺形成藍色沉澱。
3、普魯士藍法:細胞內、外鐵與酸性亞鐵氰化鉀作用,形成藍色亞鐵氰化鐵沉澱。
 細胞化學染色
細胞化學染色4、雪夫反應:過碘酸氧化細胞內糖類中乙二醇基形成乙醛基,醛基與雪夫試劑作用,使無色品紅形成紅色沉澱。
5、金屬沉著法:其他尚有物理學方法,如脂溶性染料染色(顯示脂質)、螢光顯示、放射自顯影以及體外活體染色亦常用於臨床血液細胞學診斷。
(三)細胞化學定量
粗略估量,以染色反的強弱,受色的深淺,人為地區別為陰性和各種程度的陽性。
百分法,只能反映細胞陽性率,不能反映受色強弱。
積分法,是常用的半定量法,將等級估量與百分率相結合它既反映了細胞陽性率的高低,又反映了細胞受色的強弱。
過氧化物酶染色
過氧化物酶染色
過氧化物酶染色原理
粒細胞和單核細胞的胞漿內的髓過氧化物酶(POXorMPO)分解過氧化氫,釋放新生態氧,使無色聯苯胺氧化成藍色聯苯胺,後者進一步變成棕色化合物沉著於細胞質內。
試劑
1%TMB、亞硝基鐵氰化鈉飽和溶液、1%過氧化氫溶液、稀過氧w化氫溶液、瑞氏染色液
操作
1、取0.1%TMB乙醇溶液lml,加亞硝基鐵氰化鈉飽和溶液10ml,溶液呈淡棕黃色。
2、在新鮮乾燥的血片上,加混合溶液0.5ml,放置lmin後,再加稀過氧化氫溶液0.7ml,染色6min。
3.瑞氏染液復染15~20min。
4.油鏡鏡檢。
結果
細胞質內有藍黑色顆粒者為陽性。
(-)無顆粒沉著;
(±)顆粒細小,分布稀疏;
(+)顆粒較粗,局灶分布;
(++)顆粒粗大,分布較密,占胞質1/2~2/3;
(+++)顆粒粗大,呈團塊分布;
(++++)全部胞質均部滿顆粒,可覆胞核。
臨床意義
POX主要分布在粒細胞和單核細胞內,隨著粒細胞成熟的程度而逐漸增強,中性分葉核粒細胞為強陽性。嗜酸性粒細胞陽性程度最強,其陽性顆粒比中性粒細胞粗大,有折光。鹼性粒細胞為陰性。
(2)單核細胞:
原始單核細胞為陰性反應,幼稚單核細胞和成熟單核細胞呈弱陽性反應,顆粒細小,彌散分布。
(3)其他細胞
淋巴細胞、漿細胞、幼紅細胞、組織細胞、巨核細胞均呈陰性反應。
(4)血小板過氧化物酶
主要定位於幼稚型巨核細胞的核膜上,可作為原巨核細胞的一種標誌物,有助於FABM7的識別。
(5)過氧化物酶染色
主要用於鑑別急性白血病類型,急性髓細胞白血病多呈陽性反,以M3和M2型反應最強,MI和M5型反較弱,S故有助於區別M3和M5型。S急性淋巴細胞白血病呈POX陰性反,故為急性髓細胞和淋巴細胞白血病鑑別的重要指標。
蘇丹黑B染色
蘇丹黑B染色
蘇丹黑B染色試劑
1.10%甲醛液。2.蘇丹黑B乙醇溶液
操作
1.乾燥血片或骨髓片在甲醛蒸氣中固定。
2.自來水沖洗。
3.放人染色液中,37℃染色30~60min。
4.用70%乙醇脫色1~2min,水洗lmin。
5.瑞氏染液復染20~30min。
結果
脂類呈黑色或棕黑色顆粒,定位於細胞漿中
(+)顆粒很小,細小、稀疏,或胞質局部面積的1/4有緻密的顆粒。
(++)顆粒較少,或胞質面積的1/2出現黑色顆粒。
(+++)顆粒較密,或胞質面積的3/4出現黑色顆粒。
(++++)顆粒極密,顆粒間無間隙。
臨床意義
1.粒細胞系
早幼粒及以下階段隨著細胞成熟,陽性顆粒逐漸增加。早期原粒細胞一般為陰性,少數細小點狀顆粒代表線粒體被染色晚期原粒細胞可出現陽性顆粒,其顆粒限於胞漿的某一區域。
2.單核細胞系
陽性,顆粒細小,分布彌散,形狀不規則。原單核細胞為陰性。
3.紅細胞系、淋巴細胞系均呈陰性反應。
4.尼曼一匹克細胞和戈謝細胞均為陽性反應。
5.蘇丹黑B和過氧化物酶染色臨床意義相似,主要用於急性白血病類型的鑑別。蘇丹黑B染色較過氧化物酶染色更敏感,但特異性不如過氧化物酶染色(極少數急性淋巴細胞白血病可為陽性)。
過碘酸一雪夫染色
 過碘酸一雪夫(PAS)染色
過碘酸一雪夫(PAS)染色胞漿記憶體在糖原或多糖類物質(如粘多糖、粘蛋白、糖蛋白、糖脂等)中的乙二醇基(CHOH-CHOH)經過碘酸(periodicacid)氧化,轉變為二醛基(CHO-CHO),與雪夫(Schiff)試劑中的無色品紅結合,形成紫紅色染料而沉積於胞漿中。該反應稱為過碘酸一雪夫(PAS)陽性反應。
結果
(1)粒細胞系:
原粒細胞多呈陰性反應,也可弱陽性。自早幼粒細胞以後隨著細胞的成熟程度,陽性反應逐漸增強。嗜酸粒細胞顆粒本不著色,但顆粒間的胞質呈瀰漫性陽性反應;嗜鹼粒細胞為陽性反,顆粒紫紅色,大小不一。
中性粒細胞糖原含量參考標準
(-)胞質無顆粒做生物
(+)胞質呈淡紅色,無顆粒
(++)胞質呈紅色,有少量顆粒
(+++)胞質呈暗紅色,顆粒較密
(++++)胞質呈紫紅色,顆粒極密
(2)淋巴細胞系:
大多數淋巴細胞呈陰性反應,少數為(+)的陽性反應。
淋巴細胞糖原含量程度參考標準
(-)胞質內無顆粒
(+)物胞質內有顆粒
(++)有較粗紅色顆粒
(+++)有粗大紅色顆粒
(++++)顆粒粗大並有紅色塊狀
(3)紅細胞系:
幼紅細胞和紅細胞呈陰性反應
紅細胞系列糖原含量程度參考標準
(-)胞質無顆粒om
(+)有少數紅色顆粒
(++)有較粗紅色顆粒或瀰漫紅色
(+++)有粗大紅色顆粒或深紅色
(++++)有粗大紅色塊狀或紫紅色
 巨噬細胞
巨噬細胞巨核細胞和血小板染色反均為陽性
巨核細胞糖原含量程度參考標準
(-)胞質無顆粒
(+)少量糖原包涵體
(++)中等量糖原包涵體,定位於核膜出或分散胞質中,占胞質1/3
(+++)大量糖原包涵體分散於胞質的1/2
(++++)糖原包涵體充滿整個胞質
(5)單核細胞呈陰性或陽性,顆粒細小,往往位於胞質邊緣;
漿細胞大多呈陰性,少數為紅色顆粒陽性;組織細胞為陰性反應;巨噬細胞可呈陽性,為紅色顆粒反應。
臨床意義
(1)M6與巨幼貧的鑑別
M6的幼紅細胞PAS可呈強陽性,積分明顯增高,巨貧、再障、溶貧時PAS反應為陰性。
(2)急性白血病的類型鑑別ALL,PAS呈大塊狀陽性,也可是陰性,AML為陰性,急性單核細胞白血病時原單核細胞及幼單核細胞PAS陽性,積分增高,陽性顆粒小而多,呈彌散分布。
(3)巨核細胞和Sternberg細胞鑑別巨核細胞PAS強陽性,Sternberg細胞為陰性或弱陽性。
(4)戈謝氏細胞強陽性,尼曼-皮克細胞陰性或弱陽性。
(5)淋巴肉瘤、霍奇金病等,淋巴細胞的糖原積分增高;一般的病毒感染,糖原積分在正常範圍內。
鹼性磷酸酶染色
 中性粒細胞鹼性磷酸酶染色
中性粒細胞鹼性磷酸酶染色原理
中性粒細胞胞漿中的鹼性磷酸酶在pH9.2~9.8緩衝液中,能水解磷酸萘酚鈉,並釋放出磷酸與萘酚。再以重氮鹽與萘酚偶聯成不溶性有色偶氮染料沉澱於胞漿中。
結果
堅牢藍RR陽性為紫黑色顆粒,堅牢紫醬GBC陽性為棕紅色沉澱。
一”陰性反,胞漿中無陽性染色顆粒。
+”胞漿中含有少量顆粒或呈彌散淺紅色(或彌散紫色)。
2+”胞漿中含有中等量顆粒或彌散受色。
3+”胞漿中有豐富的顆粒或彌散深色,胞核清晰。
4+”有極豐富的粗大顆粒,充滿胞漿,或彌散深色,胞核不清晰。
臨床意義
(1)生理變化:新生兒NAP增高,成人較兒童減低,老人更低;激烈運動增高;月經期經前增高,行經後降低,經後期恢復正常;妊娠期2-3月輕度增高,以後逐漸增高,分娩時達到高峰,產後恢復正常。
(2)、病理變化
增高:嚴重化膿性感染、類白血病反、AA、CML加速期、ALL、CLL、惡性淋巴瘤、癌轉移、MM、真紅、骨髓纖維化等。減低:PNH、CML、惡性組織細胞病、MDS。
(3)疾病鑑別診斷
慢粒與類白的鑑別:CML減低,類白增高。
急性白血病的鑑別:AML減低,ALL增高。
PNH與AA鑑別:PNH減低,AA增高。
病原微生物的鑑別:病毒感染減低,細菌感染增高。
